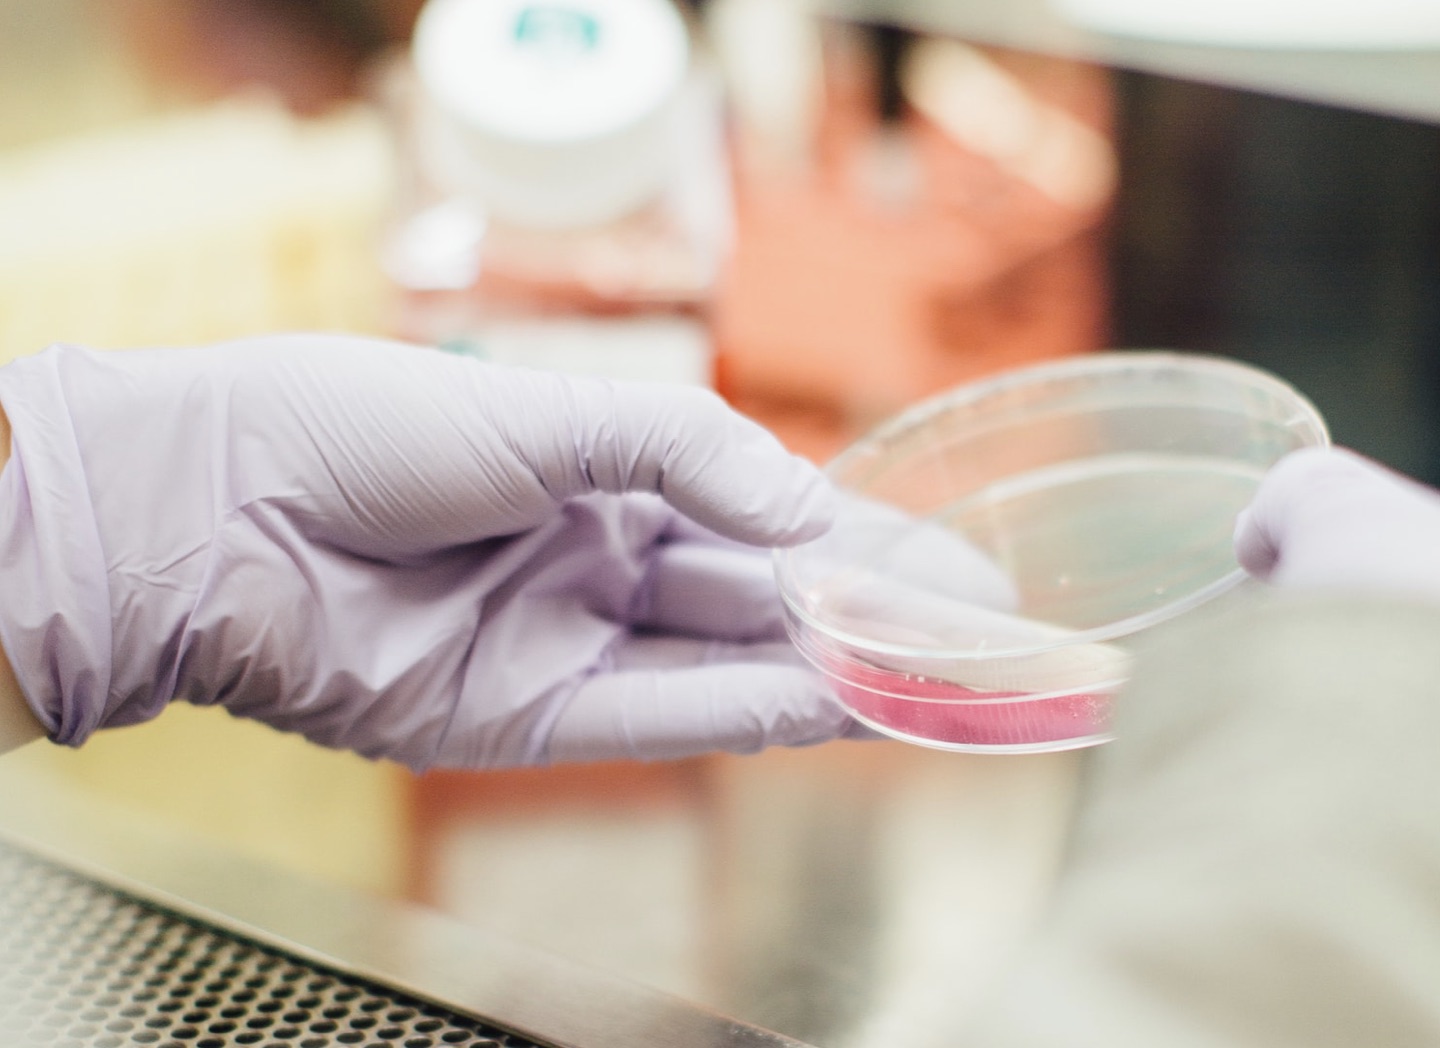

The secretome in cellular communication
Cells in the human body communicate with each other constantly by sending signals that travel outside the cell. Some of these signals are enclosed in membrane-bound corpuscules called extracellular vesicles. In the past decade, several different classes of extracellular vesicles have been characterized including one class known as exosomes.
What are exosomes?
Exosomes are released from the cell through a specific cellular pathway that involves a sorting protein complex known as ESCRT. Exosome vesicles are usually about 50 to 200 nm in diameter which makes them quite small but still spacious enough to hold molecular cargos. Indeed they have been known to contain a number of different molecules including nucleic acids, proteins, peptides, fatty acids, and metabolites. Different organs can release different types of exosomes and they also show the ability to home in to different target tissues and cell types, which suggests that they likely play very specific functions carrying parcel from one cell type to another. For the most part however, what kind of parcels they carry and what is the consequence of this signaling remains a mystery.
Exosome signals in the heart
Exosome research has received intense attention in cardiovascular medicine in the past decade. This was spurred in part by the search for cell therapies that can help heal or rejuvenate the cardiac muscle after an injury such as a heart attack. Multiple research groups have reported that after the injection of cardiomyocytes into the injured heart there is a clear improvement of cardiac output. At the same time, however, it is now known that the injected cells have a poor survival and engraftment rate in the recipient heart. Interestingly, several studies have found that simply injecting the exosomes released from heart cells into the injured heart could carry similar benefits to injecting the heart cells themselves. This suggests that the benefits of cell therapy could be due in part to the protective signals released from healthy heart cells to injured heart cells. If we could find out the identity and mechanisms of action of these protective signals, this could open new avenues to finding more precise therapies for treating injured hearts.
Hunting for exomirs
We recently worked with colleagues at Stanford Cardiovascular Institute to discover what are the micro RNA molecules that are packed inside the exosomes released from cells in the heart. Micro RNAs are an important class of nucleic acids in the cell that do not code for proteins but instead modulate the expression of other genes. Exosomes are known to contain multiple micro-RNAs that are also called exomirs (for exosomal micro RNAs). To discover the identities of the exomirs released by different types of cells in the heart, we took advantage of the power of induced pluripotent stem cells to differentiate into different cell types that compose the human heart, including cardiomyocytes, endothelial cells, and fibroblasts. Surprisingly, we found that each cell type releases exosomes that contain very different exomirs that reflect the different biology of these cell types. For instance, cardiomyocytes release exomirs that are known to be expressed primarily in the heart, whereas fibroblasts which are present in different organs in the body release exomirs that are ubiquitously expressed. This difference is so pronounced in fact that we found out we could sample the micro RNAs in a plate of cell culture and be able to guess the cell type composition in the dish. For example, detecting one type of exomir (miR-302a) in the tissue culture medium is a sensitive indication that there are undifferentiated iPSCs present in a dish of cardiomyocytes. This could lead to convenient assays to rule out potential contamination of undifferentiated cells, which is a serious concern for producing cardiomyocytes for potential human use, since these undifferentiated cells may have the potential to develop into unwanted cell types or even tumors.
To find out more about our work on cardiac secreted signals, please feel free to read our paper out in Circulation here, and a press piece written by Adrienne Mueller at the Stanford Cardiovascular Institute. You can also explore the exosome miRNA dataset on our website.
Protein secretome from the heart to other tissues
Besides its vital role in circulation, the heart has an important secondary function as an endocrine organs. A well known example is the natriuretic peptides released from cardiac cells, which can exert a wide range of physiological effects on other tissues such as the kidneys to control blood volume and pressure. In recent years, more and more proteins and peptides that are potentially released from the heart have been found in experiments, some of which may be important in human aging processes. In a recent paper, we asked how many of these heart-released proteins, or "cardiokines" there could potentially be that affects aging in other tissues of the body. To do that, we combined and analyzed large scale human data on heart-expressed transcripts as well as potential proteins in the human proteome that are released to the blood. A correlation analysis found that hundreds of cardiac transcripts could potentially change in expression levels as humans age, which could hint at important aging-related functions. More importantly, not every such gene has the same age-associated changes, with some that show different abundance only in particular tissues but not others, suggesting they could serve as a heart-specific aging signal. An exciting next step would be confirm these candidates in experimental systems such as human induced pluripotent stem cells to assess their functional impact.
Check out the mini-review on cardiokines written by Himangi and Marina at this link here!